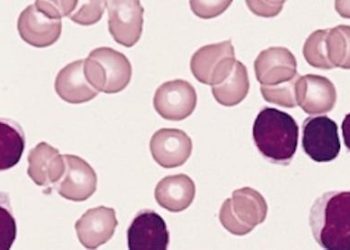
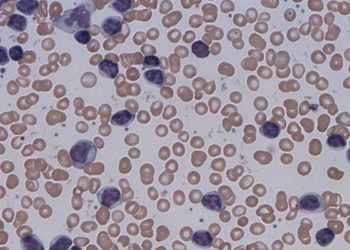

1. VENICE-1 observed high response rates (complete or partial remission) in both BCRi-naïve and BCRi-pretreated patients with refractory or relapsed CLL.
2. Neutropenia was a common treatment-related adverse effect in those treated with venetoclax.
Evidence Rating Level: 1 (Excellent)
Study Rundown: VENICE-1 was an open-label multicentered trial that assessed the efficacy of venetoclax in the treatment of relapsed or refractory chronic lymphocytic leukemia (CLL). Patients included either previously treated relapsed, or refractory CLL. The study included both those who had been previously treated with a B cell receptor-associated kinase inhibitor (BCR-i) and those who were BCR-i naive. Overall, VENICE-1 noted that 80% of the patient population assessed demonstrated a response (partial or complete remission). Strengths of this study include the long follow-up time assessed (two-year follow-up time). Further, the study was strengthened by the inclusion of both those individuals who had previously been treated with BCR-i and those who were BCR-i naïve. Limitations of this study include the lack of a control group comparator due to the single-arm design of this trial. Overall, VENICE-1 offers compelling evidence supporting the efficacy of venetoclax in patients with relapsed or refractory chronic lymphocytic leukemia, including those who have received prior B-cell receptor-associated kinase inhibitor (BCR-i) treatment and those who are BCR-i-naïve.
Click to read the study in Lancet Oncology
Relevant Reading: Efficacy of venetoclax monotherapy in patients with relapsed chronic lymphocytic leukaemia in the post-BCR inhibitor setting: a UK wide analysis
In-Depth [prospective cohort]: The VENICE-1 trial was an open-label, multicentered and single-armed trial that assessed the efficacy of venetoclax monotherapy in patients with relapsed or refractory CLL. The trial included both patients who had been previously treated with a BCR-i and those who were BCR-i naïve. Those included were those aged over 18, with diagnosed refractory or relapsed CLL. Patients who had developed Richter transformation or prolymphocytic leukemia, along with those who were previously treated with venetoclax were excluded. 258 patients were enrolled in the study. Treatment response follow-up was assessed at weeks 24,36 and 48 following treatment. The primary outcome was the complete remission rate. This included patients who had complete remission or remission with incomplete marrow recovery. Thirty-three percent of patients (84 of 258) demonstrated completed remission or remission with an incomplete bone marrow recovery rate. The complete remission rate or incomplete bone marrow recovery rate was 35% and 27% in the BCR-i naïve group and BCR-i pre-treated group, respectively. The overall response rate in those treated with BCR-i previously and those who were BCR-i naïve was 64% and 85%, respectively. In summary, VENICE-1 presents strong evidence endorsing the effectiveness of venetoclax in individuals with relapsed or refractory CLL, including both those previously treated with B-cell receptor-associated kinase inhibitors (BCR-i) and those without prior BCR-i exposure.
Image: PD
©2024 2 Minute Medicine, Inc. All rights reserved. No works may be reproduced without expressed written consent from 2 Minute Medicine, Inc. Inquire about licensing here. No article should be construed as medical advice and is not intended as such by the authors or by 2 Minute Medicine, Inc.